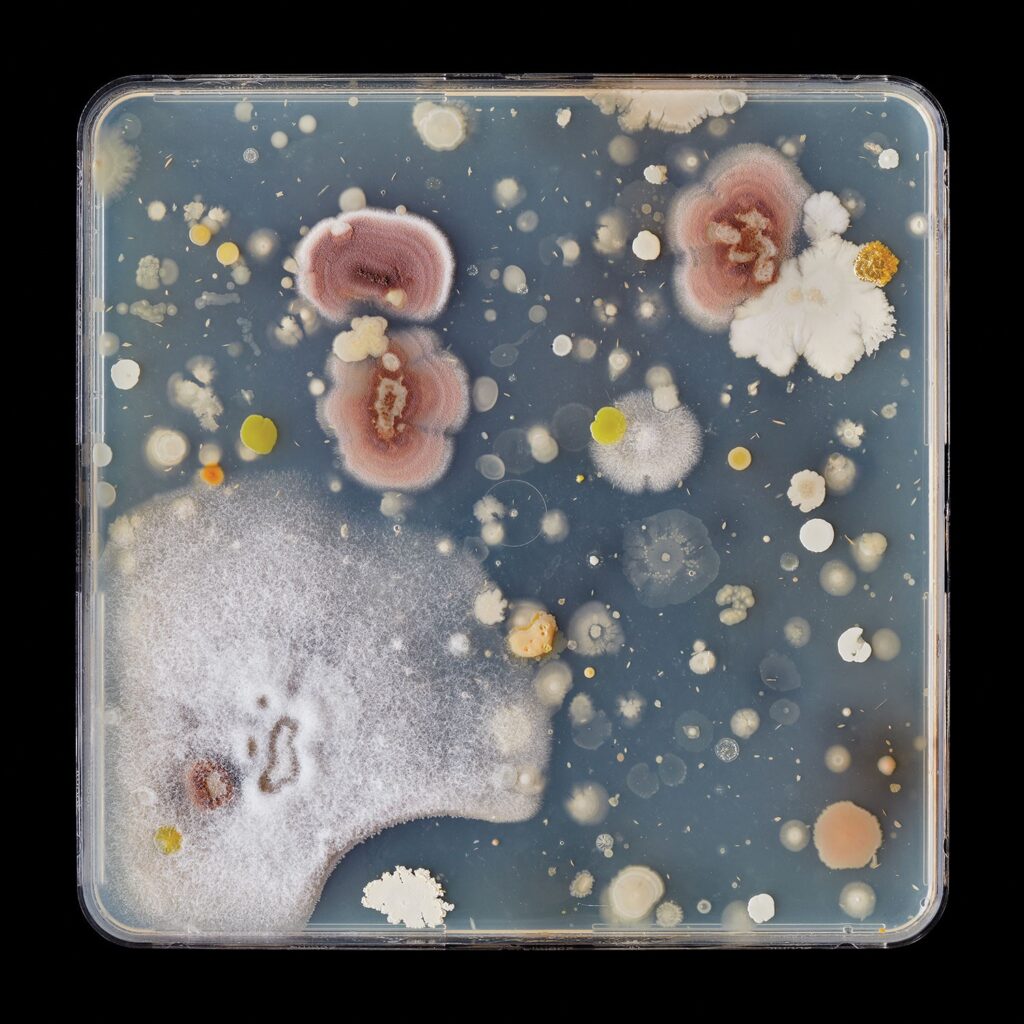
Sasaki Lead

Touring Exhibitions
The Art of Canada comes alive as our exhibitions travel from sea to sea and beyond.
Canadian art doesn’t just live in Kleinburg. The McMichael Canadian Art Collection has a long history of circulating exhibitions to cities and countries around the world. Below is an ever-changing list of our touring exhibitions that may be coming to a museum or gallery near you. Check back often and tell your friends!
All details subject to change.
Maud Lewis: Paintings for Sale
One of Canada’s most beloved folk artists, Maud Lewis (1903 – 1970) was famous in her lifetime for her brightly coloured and endearing paintings of rural Nova Scotia. Working from her cabin on the side of the highway in Marshalltown, in Digby County, she produced hundreds of small works that captured aspects of country life that were rapidly changing.

Tour Information
Itee Pootoogook: Hymns to the Silence
As one of the key members of the third generation Inuit artists from Kinngait (Cape Dorset), Pootoogook contributed to the transformation and reshaping of the creative traditions that were successfully pioneered in the second half of the 20th century by members of the West Baffin Eskimo Cooperative, at Kinngait Studios.

Tour Information

Tour Information
Tour Information
Margaux Williamson: Interiors
While women artists of the early twentieth century were known for depicting interior spaces as places of privacy and domestic quietude, Toronto artist Margaux Williamson’s (b. 1976) interiors reveal spaces of creativity, subjectivity, and a kind of anarchic experimentation.

Tour Information

Tour Information
Early Days: Indigenous Art From the McMichael
From its beginnings, the McMichael has had a long and proud history of collecting Indigenous art, now with more than 1,500 works ranging from eighteenth-century ceremonial regalia, through to items made for trade with settlers, to works by the vanguard of artists coming of age in the ’60s, ’70s and ’80s — among them Robert Houle, Carl Beam, Norval Morrisseau, Alex Janvier, Greg Staats, Faye HeavyShield and Shelly Niro — and onward to leading contemporary artists like Kent Monkman, Meryl McMaster and Rebecca Belmore.

Tour Information
Tom Thomson: North Star
Tom Thomson (1877–1917) is indisputably Canada’s preeminent modern painter, and his catalytic achievement changed the face of Canadian painting forever. This exhibition will offer a close look at Thomson’s legacy, focusing on the small en plein air oil paintings, also know as oil sketches, of which he is the supreme master.

Tour Information
Cobalt: a Mining Town and the Canadian Imagination
Cobalt, Ontario—some 500 kilometres north of Toronto—was established in 1904 following the discovery of rich silver, cobalt, ore, and nickel deposits. At peak production in 1911, Colbalt provided approximately one eighth of the world’s silver. In its heyday, the story of Cobalt was known around the world, and the town attracted miners, scientists, scholars, and of course, artists.

Tour Information
Ghosts of Canoe Lake: New Work by Marcel Dzama
Winnipeg-born Marcel Dzama’s fantastical drawings, made with ink, watercolour, and root beer, brought him international fame in the late 1990s. Now in Brooklyn, Dzama’s work includes performance, sculpture, and video. Ghosts of Canoe Lake: New Work by Marcel Dzama showcases new work inspired by Tom Thomson and the Group of Seven, and his childhood in Manitoba and Saskatchewan.

Tour Information
River of Dreams: Impressionism on the St. Lawrence
In the late 19th century, the Impressionist movement found a footing in Canada, and Quebec artists quickly responded with works of rare beauty and sophistication. This show will assemble a choice collection of master works that trace a journey from the bustling streets of Montreal—then Canada’s financial capital—down the St. Lawrence River to Quebec City and through the beloved Charlevoix region.








